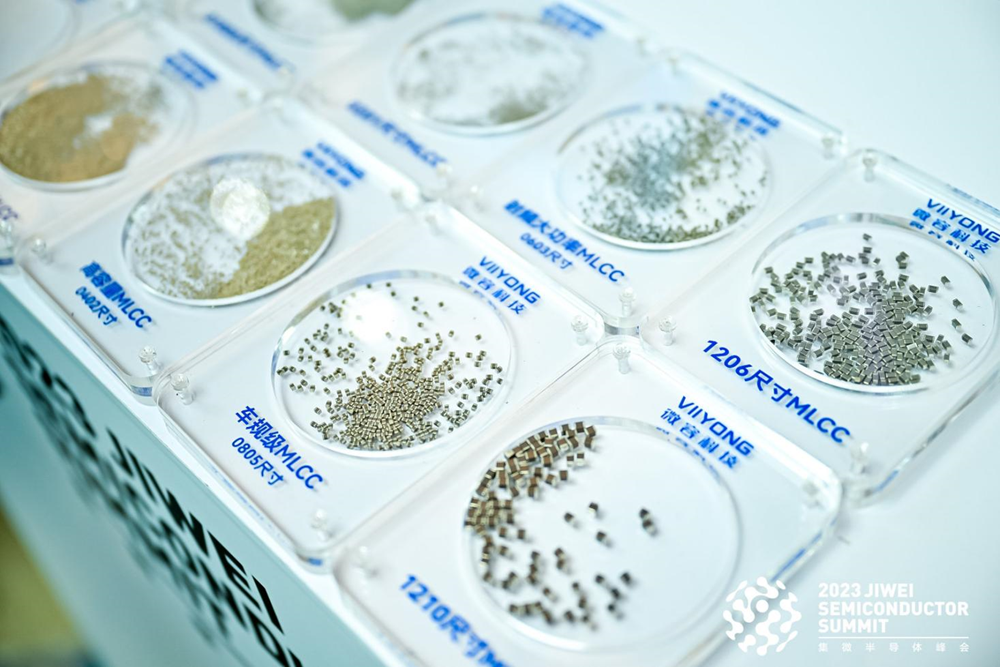

多元气质交织,让云浮在广东“高手如云”的发展版图中,走出了一条独特的“逆袭路”。如今,这座山间小城更乘“AI+养殖”的东风,在新赛道上跑出了加速度。
所谓“无鸡不成宴”,鸡是广东餐桌常驻嘉宾。广东人不仅会吃鸡,更会养鸡,养出了全国闻名的完整链条。将这一传统发挥到极致的,正是从云浮起步的温氏集团——它不仅是市值千亿的行业龙头,去年更卖出12亿只鸡,市占率全国第一。
当前沿科技,遇上传统优势产业,将催生出全新的智慧养殖。青春云浮,善作善成——这会是又一个“小块头有大作为”的故事吗?
AI叩开传统养殖的新大门
在从“山区思维”转向“湾区思维”的过程中,云浮争先进位、跨越发展,涌现了具有地域特色的“单项冠军”,孕育了粤东西北唯一一家全国500强企业——温氏食品。
从云浮启航的温氏集团,四十年筚路蓝缕,从名不见经传的乡村企业,成长为市值千亿的行业农头。在鸡肉市场,温氏的市占率已做到国内第一,去年共卖了12亿只,是名副其实的“广东最会养鸡的人”。
从传统散养模式,升级为现代化高效生态养殖;从服务本地农户,到辐射全国4万多合作农户,温氏创造了我国农业发展史的一个传奇——支撑这份跨越的,是刻在温氏基因里的“技术执念”。

青山绿水间的生态养殖小区。
文化、模式、技术和责任构成了温氏的四大驱动力。早在20世纪90年代初,温氏就埋下了数字化的种子:聚集生物技术、IT技术、管理技术人才,探索养殖全流程的信息化变革。“在数字化驱动下,温氏正加速实现产业链各个环节的价值提升。”温氏集团数字流程部负责人曾这样概括技术的力量。
如今温氏的生态养殖小区里,小鸡吃的是精心配置的“营养餐”,住的是智能管理的“高档环境”:全自动喂料、饮水、清粪、环控等设备一应俱全。物联网传感器实时捕捉温度、湿度等关键指标,并自动调控,确保肉鸡始终拥有最舒适的生长环境。至于小鸡们过得怎么样?长多重了?养殖户在手机App上一目了然——这些奔忙的景象,正是温氏向“智慧农业”转型的缩影。
正是在这套体系下,高效养殖得以实现:一个人能养20万鸡,3个人就能轻松照顾88万只鸡。
AI的到来,让这场农牧数字化转型再次迎来关键跃升。
近日,华为全联接大会2025在上海启幕,温氏股份总裁黎少松带着“数智温氏、AI养殖新范式”的主题演讲亮相,引发业内外广泛关注。大会上,温氏被列为华为全球智慧养殖样板点,与智慧工厂、智慧酒店、智慧文旅、智慧园区等领域的标杆企业同台。
这份实力并非一蹴而就。在过去几年,温氏集团依托华为数智基础设施,搭建起覆盖养殖单元的智能物联网体系,原本分散在育种、养殖、饲料、环保等环节的“数据孤岛”被打通,为AI分析与决策筑牢了基础。
如今,双方进一步合作,在养殖关键环节引入AI技术,搭建起“训推一体化平台”,让“AI养鸡”从概念变成了日常。
AI养鸡,到底有多聪明?
“与华为的深度合作,为温氏数字化转型提供了专业组织保障。”黎少松在大会上重点介绍的三大AI产品,正是温氏“数智养殖”的重要底气。
“牧视通”通过应用视觉AI技术,革新农户服务作战模式业务转变,实现空间、时间、管理三大维度革新,以及农户服务三大突破;“AI兽医”打通AI诊疗全链路,重塑疾病管理模式,实现人机高度协作,成为国内首个“执业级”AI兽医师;种猪场“六无”场景:借助AI技术,实现无人查情、无人评膘、无人调料、无人估重、无人点数以及无纸化。
技术的突破,最终要落到农户受益上。
四十年来,温氏始终为合作农户提供全链条支持:既提供生产要素、技术、管理与市场服务,又推进农业产业一体化、园区化与规模化发展,还培育合作农户转型为懂技术、善管理的新型职业农民。

温氏受邀参加华为全联接大会2025。
如今有了AI,无论是合作多年的老农户,还是刚入行的“小白”,都将进一步享受便利的现代化养殖。
稔村镇的刘伙强就是智能化养殖的受益者之一。与温氏合作的九年里,他的鸡舍从1栋平养舍,扩到4栋双层高效舍;喂养方式从人工添料,变成温控、通风、投喂全自动化。“规模大了,反而更轻松了。”刘伙强的感慨,道出了许多农户对科技赋能的共同体会。
试想一下,当广东人代代积累下来的“养鸡经”,与现代AI技术结合后,会为行业带来怎样的高效“开挂”?
具体来看,AI将以全周期赋能的方式赋能养殖:
养殖前,AI就能通过数据分析为农户“画像”,精准推荐农户适养品种并预判风险;
养殖中,AI系统根据养殖物的生长阶段、健康状况,自动调配饲料成分,实现精准投喂,让每一份饲料都产生最大价值。
管理上,AI将辅助甚至接手点数、查情、评膘等耗时耗力的工作,依托华为为温氏集团提供的技术支持,自动化查情准确率可达92%,群体估重准确率超过95%,智能设备通道联动AI计数,计算机视觉算法实现高精度背膘测量。

温氏被列为华为全球智慧养殖样板点,与智慧工厂、智慧酒店、智慧文旅、智慧园区等领域的标杆企业同台。
值得一提的是,畜禽的异常声音和行为都逃不过AI的“法眼”,全天候的远程诊疗系统,容纳了温氏数十年积累的药物、诊疗配方、处方等数据,能快速诊断疾病、发出预警并推荐处方。
数据亦是生产力。每一头猪、每一只鸡、每一栋栏舍的信息,都能在屏幕上实时呈现。这些海量的“活数据”,不仅是管理的“眼睛”,更将转化为农户和管理者决策的“智囊”。
可以想见,“凭经验喂鸡”与“靠数据养鸡”的结合,即更高效的人机协作,将把4万多合作农户从繁琐的人工操作中解放出来,直接助力生产力及一线作业效率提升。
不止于养殖
AI与养殖的碰撞,只是云浮后发赶超的一个缩影。这座曾被认为“存在感不强”的城市,正在更多领域打破偏见,交出亮眼答卷。
教育民生上,北京师范大学云浮实验学校于今年7月正式破土动工,粤东西北地区首所“北师大系”学校从蓝图走向现实;四年间,云浮兑现“资源经济收益的一半用于补齐民生短板”的承诺,新建了84所学校,新增学位7万+,撤并184个“小散弱”教学点,推动组建教育集团33个、城乡教育共同体16个,堪称再造一座“教育新城”。
城市品质上,云浮于今年8月入选“联合国可持续城市标准示范区”综合试点,成了首个在城市、社区、产业三个层面综合开展示范建设的城市;2025年,还拿下第七届“法治政府奖”,在广东省营商环境评价中首次冲进全省第二档,走在粤东西北地市前列。
产业发展上,目前云浮手握百亿级项目7个、50亿至100亿级项目11个,正全力打造绿色建材、金属智造、现代农业三大千亿级产业集群。通过纵深推进“东融湾区、西接RCEP”战略,不断拓展高水平开放的新空间。
一桩桩实绩证明,昨日的短板,已化作今日的潜力。云浮,绝非“没有存在感”的城市,而是“可干事、能成事”的好地方。
扎根罗定的微容科技,也借着AI带动的“数智改造”浪潮,迎来了高端MLCC需求增长的新机遇。
透过年月,禅宗源流、石都风华、南江文脉,交织成云浮独有的岭南味。
赢得岭南祖地、六祖故里、中国禅都、中国石都、东方硫都、西江明珠、中国肉桂之乡、中国不锈钢餐厨具之乡、中国竹蒸笼之乡、国家园林城市等标签……云浮修炼出人文、生态、区位、资源等四大优势。
且看今朝,它有“美丽宜业之城”的幸福感,“云山青水翠满城”的风貌格局,“精致经典宜人”的城市气质——古老又青春,沉稳又昂扬,塑造出云浮善德务实的城市品格。
AI与传统农业的有机融合,打破了“后发地区难在高科技领域发力”的固有认知,这份“敢闯敢试”的品格,也孕育出更多本地新锐力量:
广东盈海科技有限公司生于云浮本土,在智慧城市、基层治理、农业监测等领域打造出成熟案例;今年9月,全球首台AI纯电无人推土机在云浮市云硫矿业“上岗”,为绿色矿山、智慧矿山建设注入新动能;扎根罗定的微容科技,也借着AI带动的“数智改造”浪潮,迎来了高端MLCC需求增长的新机遇。
如今的云浮,正以“AI+养殖”为新锚点,朝着“千亿农业产业集群”的目标迈进——有理由期待,这座“小块头”城市,将为广东乃至全国带来更多“小而精、专而新”的惊喜与可能。
参考资料:
[1]最会吃鸡的广东人,开始用AI养鸡了.城市漫游计划2025-9-25
[2]温氏股份:打造共富产业链助力乡村产业兴.南方日报.2024-09-26
[3]数智温氏,集团总裁黎少松受邀参加华为HC大会并做主题演讲.温氏股份.2025-9-20
[4]养殖致富,他们为何坚定与温氏同行?南方+.2024-12-09
[5]“潜力板”崛起,云浮不可小觑.南方+.2025-7-12
话题研究员/制图:南方+记者 崔洪铭
订阅后可查看全文(剩余80%)



